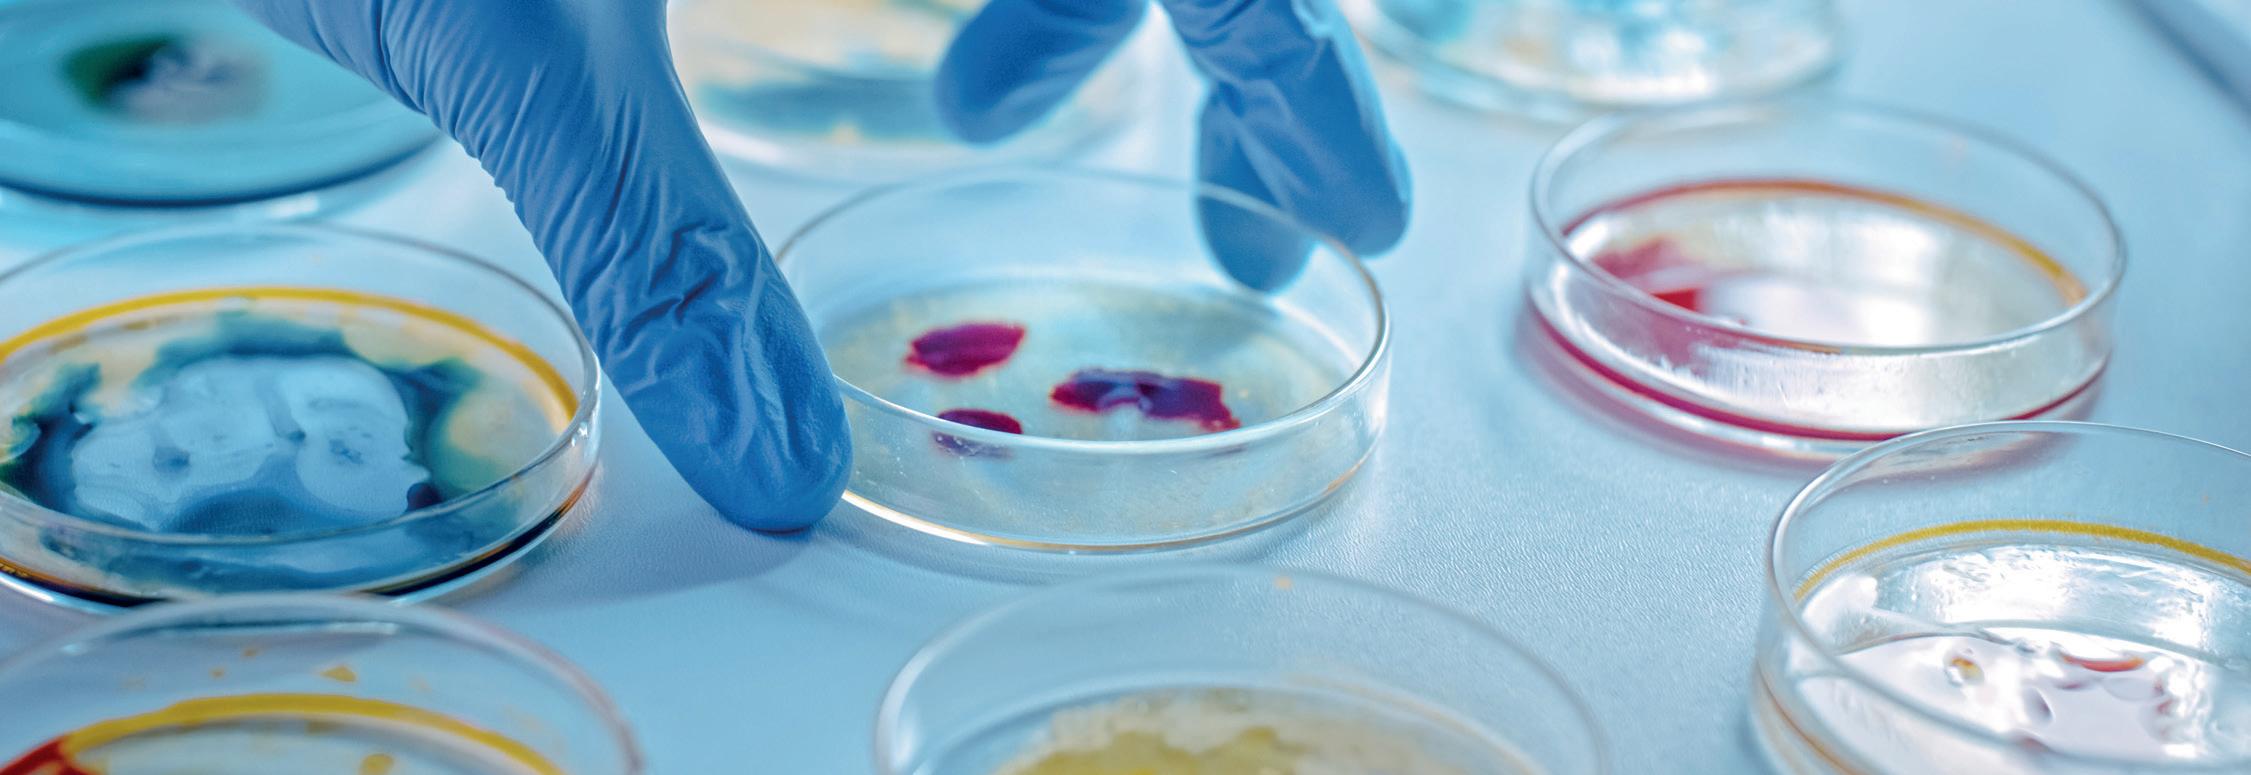

Care News AUTUMN 2022
Welcome to our Autumn newsletter. So much has happened since our Summer issue – we’ve had heatwaves, a cost-of-living crisis, and a new Prime Minister. We also have a new monarch for the first time in 70 years, and Albert Goodman wishes to express our sadness at the loss of Her Majesty Queen Elizabeth II earlier this month.
All these factors will affect care businesses, their staff, and the people they support. Government policy and regulation is one of the main issues which providers must consider, and so we have dedicated this issue to some of the main areas of regulation with support from several new contributing colleagues. Carl May-Smith, Partner at Browne Jacobson, outlines current trends in the Care Quality Commission (CQC)’s inspections and its new framework, whilst Denizns have demystified international recruitment and Opeque explain the new rules for Infection Prevention and Control.
We hope you enjoy the issue.
Partner, Head of Charities and Care, Albert Goodman

Welcome GOVERNMENT DATA STRATEGY
TO IMPROVE OUTCOMES
In June, the Government launched a new data strategy for health and social care which will, it hopes, help improve outcomes for millions of patients. The strategy is titled Data Saves Lives: Reshaping Health and Social Care with Data, and focuses on seven broad commitments:
Improving trust in the health and care systems’ use of data
Giving health and care professionals the information they need to provide the best care
Improving data for adult social care
Supporting local decision makers with data
Empowering researchers with the data they need to develop life-changing treatments and diagnostics
Working with partners to develop innovations that improve health and care
Developing the right technical infrastructure
Launching the strategy at London Tech Week’s HealthTech Summit, former Secretary for Health & Social Care Sajid Javid said that the Government would, “work with the public, including people working in health and care, to develop a new pact on data, which will set out how we will use health and care data, and what the public has the right to expect. This will include the ability to opt out of sharing data. Because although we know that most people want their data to be used for good, we will make the opt-out system simpler and more transparent.” He went on to say that social care lags behind the NHS when it comes to digital transformation, something which he aimed to change.
Michelle Ferris
HEALTH AND CARE REGULATION
- Current Trends in CQC Inspections
The last few years have seen substantial changes in how health and care is regulated. The pandemic forced the CQC to move away from routine inspections, with hastily-prepared alternative models of regulation seeking to identify providers of greatest concern at the expense of broader scrutiny and an up-to-date view of the quality of services across the sector. With those models now gone Carl May-Smith, partner and barrister at Browne Jacobson, shares his thoughts on current trends in inspections.
One of the headlines in the CQC’s strategy for 2021 and beyond was a desire to increase the standards expected for care to be classed as ‘Good’. From our recent experiences, this direction of travel has already begun to affect provider ratings. Inspection reports that would have produced overall ‘Good’ ratings previously are now attracting ratings of ‘Requires Improvement’. 44% of the overall ratings given in the last month were ‘Requires Improvement’ or below, compared to 14% of the most recent ratings over all services. This is something that lenders, insurers and investors will need to bear in mind when comparing more recent ratings with previous expectations.
Are there other factors driving the increased proportion of lower ratings? One key factor is almost certainly the way that the CQC is prioritising inspection activities. It is focusing those activities predominantly on services where there are concerns. This not only means that they are more likely to be inspecting lower-quality services, but also that inspectors’ initial approach is likely to be a sceptical one. Services where there are no concerns, even those with lower ratings that may deserve improved ones, are waiting a very long time for inspections despite the CQC’s aim to address the issue.
Other factors may include the fact that relatively little allowance appears to be being given by the CQC for challenges that arose during more intense periods of the pandemic, particularly where providers are still in the process of addressing staffing shortages, backlogs or the reintroduction of services.
There is also a need for providers to adapt to the CQC’s new priorities. Greater emphasis on people’s experiences of care has not yet been matched with a broader or more methodical approach to collecting feedback. The result is that one negative account can have a disproportionate effect on inspection outcomes. Providers can protect themselves from this by being proactive in collecting feedback from people using the services and their families.
The management of Covid risks has moved on from some of the more detailed national guidance to a period where decisions around management are expected to be much more service-specific. The CQC may identify an additional risk within a service and challenge providers to show that it has been addressed, even where that means considering going beyond the requirements of any national guidance.
Services have innovated, adapting to changes in the care environment and staffing shortages, along with other challenges. Where successful, this has been achieved without any detriment to outcomes. However, the CQC’s

aspiration to benchmark providers against other similar services remains just that. For the time being services will still be measured against their own internal aspirations. Where adaptations have been necessary, it is vital that is reflected in written policies and procedures.
Carl May-Smith can be contacted at: carl.may-smith@brownejacobson.com, telephone 0115 934 2024 https://www.brownejacobson.com/health
Demystifying International Recruitment
With over 105,000 vacancies in social care every day, and 1.54 million staff working in the sector as a whole, recruiting and retaining staff is a constant worry for care providers. Of these 1.54m staff, 7% come from countries in the EU, with a further 9% coming from countries outside the EU. International recruitment may seem daunting, but as Mithun Mohan from Denizns explains, by following a simple process it doesn’t have to be.
Recruiting staff from abroad requires a significant effort on the part of the employer to educate everyone in the organisation from the top down. Recruitment is about more than just numbers, if it is done correctly employers can nurture staff who become huge fans of your care home brand, and nowhere is this more true than with international staff.
Many employers have qualms about international recruitment which can include that it is complex, prone to difficulties/culture clashes, and costly. Whilst these are understandable, there are counterarguments to these qualms. For example, whilst there are legal requirements to meet when employing staff from overseas this process is often made overly complex by international recruiters, who insert numerous clauses to their contracts. Similarly, many of the ‘horror stories’ are heard third hand rather than as direct experience, and there are also costs to recruiting in the UK such as advertising and agency fees. When recruiting internationally, we typically offer employers between 10 and 20 candidates for each vacancy, and we advise employers to use a ‘step by step’ process to demystify international recruitment and make it part of their standard recruitment and retention strategy.
STEP 1: Ascertain your requirements – revisit your current processes, people and technology. Do you have adequate systems to manage applications? Ensure that your recruitment paperwork is correct and complete.
STEP 2: Work out your costs (one-off and yearly). This should include salaries (taking overseas thresholds into consideration), application fees, and payments to sub-contractors such as recruitment agencies.
STEP 3: Envision the logistics. You should create an ecosystem around your care home, taking into account accommodation for your staff. Can they be accommodated on-site or nearby?

STEP 4: Define the scope of the suppliers (agencies) you would like to work with.
STEP 5: Source your suppliers, not only for recruitment but also for legal services and logistics.
STEP 6: Application phase
STEP 7: All recruitment is GO!
Throughout this process, remember TREADS: Transparency, Resilience, Empathy, Accountability, Diligence, and Stewardship. Also bear in mind that it is better to recruit experiences than staff – if your new staff have a good experience, they will become your best advocates and encourage others to join, making the recruitment and retention process much easier.
For more information about recruiting internationally, email hello@denizns.co.uk or telephone 01908 737 007.
CQC’S
NEW INSPECTION
FRAMEWORK
It now appears that for most providers, the CQC’s new approach will be finalised and its new inspection framework will appear in January 2023. Carl May-Smith, partner and barrister at Browne Jacobson, outlines what it is likely to look like.
The CQC is developing a new inspection framework targeting implementation in January 2023, following on from various trials with early adopters which began recently (August 2022).
What is being prepared is a single inspection framework covering heath and care providers and the integration and commissioning roles of Integrated Care Systems and local authorities. The CQC are being given new powers to assess the latter two categories of organisation, and it is hoped that this may address previous provider concerns that they were punished by the CQC for issues that, in fact, arose from commissioning errors or inadequacies.
Point-in-time ratings stemming from set-piece inspections are to be replaced by ongoing multi-point assessments, delivering on the aim for more responsive service ratings. As a result, ratings may change much more often.
Additional sources of information will be utilised, particularly in relation to feedback from people experiencing care, care workers and partners in care pathways. Internal CQC ‘dynamic dashboards’ will inform regulatory action. More detailed, easier-to-digest information will be made available to the public, and even more given to providers to allow them to prioritise areas for improvement.
Long narrative inspection reports are to be replaced with scores, short statements and benchmarking of provision and outcomes against other comparable providers. The latter, if implemented well, could be one of the most significant positive impacts of these reforms; with ambitious providers no longer being criticised for failing to meet their own ambitious targets despite matching or exceeding the levels achieved by their competitors.
The five key CQC questions, Safe, Effective, Caring, Responsive and Well-Led, will remain but will now be complemented by ‘I statements’ describing how people should experience care, such as “When I move between services, there is a plan for what happens next.”
Below that, the current 300+ ‘Key Lines of Enquiry’ will be replaced by 34 ‘Quality Statements’ focusing on how care
is provided. Each Statement will sit under a Key Question and be scored from one to four. The aggregate scores will determine the rating for that Key Question. In this way ratings can be changed without reassessment of the service as a whole. Where the CQC receives information relating to one or a small number of Quality Statements, it can update those scores and then reassess the aggregate and therefore the rating.
As well as the feedback described above, observation of care (or inspection) will remain an important part of assessing most services. However, processes, policies and procedures will no longer be assessed on-site, but through remote collection of information from providers. Outcomes will also be given a much greater emphasis under the new framework.
If you want to get some insight into how this framework has been developed, visit www.thinklocalactpersonal.org.uk/ makingitreal. The CQC has itself stated that it has borrowed heavily from this approach, to ensure that the framework does all it can to promote personalisation.
Choice, control and personalisation are said to be a golden thread throughout the new approach, with closed cultures remaining a key focus. This is alongside greater emphasis on safety culture, learning & improvement, listening to people’s voices, workforce wellbeing, equity of access, experience & outcomes and sustainability of services and the environment.
Overall, I am enthused by the CQC’s ambition. It offers a clearer way for providers to see how their rating is reached and can be improved. There will be greater transparency for the public. Benchmarking and dynamic re-rating offer real rewards for high quality and improving services.
As ever the key will be implementation. If my descriptions of how feedback will be collected, what data will be compiled and how benchmarking will work seem vague, that is because there is much to come in the detail of this approach. However, for now, I remain positive.
Carl May-Smith can be contacted at: carl.may-smith@brownejacobson.com
Telephone 0115 934 2024
https://www.brownejacobson.com/health
CAN A REDUCTION IN VAT CURB INFLATION AND HELP HOUSEHOLDS?
During the summer Steve Chamberlain, VAT Senior Manager at Albert Goodman, shared his thoughts about the possibility of the Government cutting the rate of VAT as a response to the cost of living crisis. With Liz Truss’ plans yet to be confirmed, we have reproduced Steve’s article here as his points remain useful.
If the Government has funds available, I hope it will spend them in a way that gives the best benefit per £ spent. I don’t see that an across-the-board reduction in the standard- rate VAT will do that. Rather, and I write this after fuel protests on the M5, I suggest that the Government introduces a temporary rate of VAT on road fuel for private vehicles.
THE PROBLEM
Between December 2008 and January 2010, the standard rate of VAT was reduced during the “credit crunch” with the aim of boosting consumer spending and thus the economy. There’s little evidence that this was of great assistance, and the rate of VAT was subsequently increased to 20% in January 2011.
A key issue is that, absent any specific legislation, businesses are not obliged to reduce their prices and pass the savings from a cut in VAT onto consumers. During the pandemic, for example, VAT was temporarily reduced to help the hospitality industry. Not all takeaways or restaurants reduced their prices. As the stated driver for the VAT reduction was to preserve jobs and businesses suffering as a result of lockdown, I personally thought this was OK.
Further, not all of my household expenses that are rocketing up are subject to standard-rate VAT. My mortgage isn’t subject to VAT. My gas and electricity bill is subject to VAT, but at 5%. If this goes up by £1000, only £50 of the increase is VAT, so if the Government zero-rates domestic fuel and power, the whole benefit is a cost to the Exchequer and doesn’t save me a massive sum.
A SOLUTION?
Better, I think, if the Government can reduce VAT on road fuel for private motoring.

Back when a litre of petrol could be purchased for £1.20, the Government received 20p by way of VAT. If petrol is currently (and I wonder how long it will be before this figure is out of date) £1.92, the Government receives 32p by way of VAT. The pre-VAT figure is £1.60. If the rate of VAT on petrol was reduced to 12.5% the Government would still receive its 20p on a pre-VAT price of £1.60. So long as the petrol retailer reduces its price to reflect the VAT reduction, I’d pay £1.80 per litre.
On the basis that consumers closely monitor the price of fuel, it should be difficult for a retailer not to pass on the VAT savings. After all, petrol is specifically sold by the litre. A retailer cannot just alter the “pack size” to meet a given price point. I did buy a multi-pack of my favourite confectionery at the weekend for a promotional price. Then noticed that the product was only about half the size that I remember it…
Steve Chamberlain can be contacted at steve.chamberlain@albertgoodman.co.uk or by telephone on 01823 286096.


INFECTION PREVENTION AND CONTROL (IPC)
– A Reality Check on the latest Government Guidance
In April, the Government published new guidance on Infection Prevention and Control (IPC). Richard Newton of Opeque explains what it means for care home owners.
The new Government guidance for Care Homes published in April 2022 is no different in principle to the 2013 Department of Health document, but the content is re-packaged and provides far greater emphasis and instruction on the need to control and reduce the risks posed by infections.
The root causes of infection are manifold and whilst clinical in essence, the vectors for their transmission are physical and procedures must be correctly managed. Much has been learnt over the last few years, and we should now be prepared to implement the required procedures to keep safe at all times. Beyond Covid, what exactly is the future strategy and skills pathway for Infection Prevention and Control, Risk Management and Safety Culture Excellence in your Care Home?
Antimicrobial resistance is a global problem that makes infections harder to treat with existing medicines. High standards of IPC reduce the opportunities for infections to spread and for resistance to develop, which is why the guidance has been developed. You can read more about it here:
https://www.gov.uk/government/publications/infection-prevention-and-control-in-adult-social-care-settings/infectionprevention-and-control-resource-for-adult-social-care
IPC measures which care homes should consider include:
Antimicrobial fabric treatments for the laundering of bed linen, towels, staff uniforms and residents’ clothing. This provides a residual long lasting anti-viral and anti-bacterial quality, to ensure that all fabrics are hygienically clean and will not allow the transmission of sources of infection
Ozone generators for water treatment, laundry processing, room/air purification and cleaning of fabric/clothes
Copper Silver ionisation based water treatment systems for controlling Legionella Pneumophila, Pseudonomas Aeruginosa and other water borne bacteria. Water storage and distribution systems should be surveyed to ensure that the correct equipment is specified and installed
Copper cover antimicrobial surface treatment for handles and push plates. This is an age- old principle of deploying the antimicrobial properties of copper, applied to surfaces using current state of the art technology
Laundry machinery, process specification, detergent supply and hygiene quality diagnostics.
Opeque has previously worked with hundreds of care homes, providing direct services as a supplier of laundry equipment, along with its operation and servicing requirements; water treatment systems for Legionella control; antimicrobial treatments for fabrics, soft furnishings and hard surfaces and general hygiene control through the use of ozone generators. Its team is complemented by access to many healthcare and microbiological experts, and includes a vastly experienced carer and nurse to ensure a reality check is applied to the technical approach.
In addition to the IPC measures outlined above, Opeque can also provide buildings and services M&E installation and maintenance services; energy surveying to identify cost reduction opportunities; energy and utility supplies procurement and carbon footprinting/sustainability analysis to produce your net zero strategy.
Contact Opeque at richard@opeque.com, telephone 07831 873355 or visit www.opeque.com. You can also meet the team at an upcoming event: https://carehomesipc.co.uk/ and https://www.careroadshows.co.uk/exhibitors-london/
As we reach the end of another edition of the Care Newsletter, we are very grateful to our colleagues across the sector for offering their expertise in various areas such as law, infection control, and recruitment. By providing these articles they enable us to offer you a publication which we hope gives you a ‘one stop shop’ for some of the main issues affecting care providers. Please do get in touch if you would like us to address something in particular, we are always delighted to speak to readers.
As we turn our attention to the coming months we hope that the articles within this edition will help you to manage the autumn and winter period, which are always more challenging in the care sector. Albert Goodman is keen to support providers to be as efficient as possible in terms of planning, payroll, and tax advice, so please contact us for further assistance.
Until next time, Michelle Ferris

Head of Charities and Care, Albert Goodman
30th September ‘World’s Biggest Coffee Morning’ for Macmillan
1st October International Day of Older Persons
12th - 13th October Care Show (NEC Birmingham)

(to release ‘hidden’ tax
advisory, restructure, succession and exit planning)
End note DID YOU KNOW...? Albert Goodman can provide your care business with: Accounts and Audit compliance Consultancy for business development/growth Acquisition and sales advice Property Capital Allowance reviews
reliefs) Corporate and personal tax services for owners (compliance,
Later Life Care funding solutions Corporate Finance including valuations and due diligence for acquisitions and sales Workplace pensions Payroll Bookkeeping Outsourcing App Advisory CONTRIBUTING TO YOUR SUCCESS If you would like to discuss any matters in this newsletter please get in touch with your usual Albert Goodman contact or Michelle Ferris direct. michelle.ferris@albertgoodman.co.uk 01823 286096 www.albertgoodman.co.uk @AG_LLP 1st - 30th September World Alzheimer’s Month
Dates for your diary
